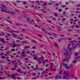
Enfermedad relacionada con inmunoglobulina IG4

La autoexploración mamaria es una práctica fundamental en la salud de las mujeres, ya que permite que la propia paciente realice una exploración de sus mamas con el objetivo de detectar posibles anomalías. Esta técnica es importante por varias razones:
- Detección temprana de problemas: Una de las razones más cruciales para realizar la autoexploración mamaria es la detección temprana de problemas mamarios, como bultos, masas o cambios en la textura de los senos. Muchas enfermedades mamarias, incluido el cáncer de mama, son más tratables y tienen mejores pronósticos cuando se detectan en sus etapas iniciales. La autoexploración proporciona a las mujeres una herramienta para identificar posibles problemas a tiempo.
- Conocimiento del propio cuerpo: La autoexploración mamaria fomenta el conocimiento del propio cuerpo. Las mujeres que se familiarizan con la textura y la apariencia normal de sus mamas están mejor preparadas para notar cualquier cambio inusual. Esto les permite ser proactivas en su salud mamaria y buscar atención médica si es necesario.
- Control y participación en la salud: La autoexploración pone el control de la salud mamaria en manos de la paciente. Les permite tomar medidas activas para monitorear su bienestar y estar al tanto de cualquier cambio que puedan experimentar en sus mamas. Esto fomenta la autonomía y la participación en su cuidado médico.
- Reducción de la ansiedad: Realizar una autoexploración regular puede reducir la ansiedad relacionada con la salud mamaria. Muchas mujeres experimentan preocupación o ansiedad por posibles problemas en sus senos, y la autoexploración brinda una forma concreta de abordar esas preocupaciones al detectar problemas potenciales o confirmar que todo está normal.
- Complemento de otras evaluaciones médicas: La autoexploración mamaria no reemplaza otros métodos de detección, como la mamografía o el examen clínico realizado por un médico. En cambio, se complementa con estas evaluaciones médicas regulares. La autoexploración puede ayudar a identificar problemas entre las citas médicas programadas.
- Educación y conciencia: La autoexploración mamaria también es una oportunidad para la educación y la conciencia sobre la salud mamaria. Las mujeres pueden aprender cómo realizar una autoexploración adecuada, cuándo hacerlo (generalmente una vez al mes, después de la menstruación), y qué buscar. Esta conciencia puede tener un impacto significativo en la salud de las mujeres a lo largo de sus vidas.
Los estudios demuestran que la autoexploracion mamaria aumenta la frecuencia con que se llevan a cabo pruebas diagnósticas de mastopatía benigna, pero carece de eficacia en la reducción de las tasas de mortalidad por cáncer mamario.